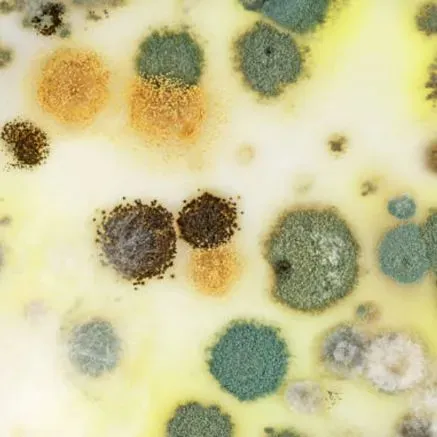
Mold Removal

DEPENDABLE EMERGENCY SERVICE
LOCALLY OWNED AND OPERATED
See What Our Customers Think About US
★ ★ ★ ★ ★
We had major mold damage hidden in our mudroom that caused our floor to collapse. We have only positive things to say about United Cleaning and Restoration. From the very beginning of our experience through project completion we have been absolutely delighted with the kindness, excellent customer service, competitive quote, timely responses, quality workmanship and a high level of ethics with a commitment to customer satisfaction at every level. Thank you for the great work!
Chris N.
★ ★ ★ ★ ★
United Cleaning & Restoration helped come up with the design and then the demo and installation for both of my bathrooms. The tile work, plumbing, and everything in between is some of the best I’ve seen and made a stressful project into a painless one. The team was always responsive and I couldn’t be any happier with the outcome of our cool and modern bathrooms! In fact, United Cleaning came back to help on a window project, which of course, came out super awesome!
Mark Z.
★ ★ ★ ★ ★
I have dealt with United Cleaning and Restoration for the past 5 years. I am in the property management industry. They are by far the best company to use from Catastrophic situations and cleaning up to rebuilds. Their prices are fair and work is impeccable. Their employees are the best in the industry as well as empathetic and understanding.
Stephanie H.